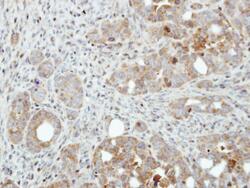

Antibody data
- Antibody Data
- Antigen structure
- References [0]
- Comments [0]
- Validations
- Immunocytochemistry [2]
- Immunohistochemistry [3]
Submit
Validation data
Reference
Comment
Report error
- Product number
- PA5-28648 - Provider product page

- Provider
- Invitrogen Antibodies
- Product name
- PFKFB4 Polyclonal Antibody
- Antibody type
- Polyclonal
- Antigen
- Recombinant full-length protein
- Description
- Recommended positive controls: Raji, mouse liver, rat liver. Predicted reactivity: Mouse (97%), Rat (97%), Xenopus laevis (85%), Chicken (86%), Bovine (99%). Store product as a concentrated solution. Centrifuge briefly prior to opening the vial.
- Reactivity
- Human, Mouse, Rat
- Host
- Rabbit
- Isotype
- IgG
- Vial size
- 100 μL
- Concentration
- 0.73 mg/mL
- Storage
- Store at 4°C short term. For long term storage, store at -20°C, avoiding freeze/thaw cycles.
No comments: Submit comment
Supportive validation
- Submitted by
- Invitrogen Antibodies (provider)
- Main image

- Experimental details
- PFKFB4 Polyclonal Antibody detects PFKFB4 protein at cytoplasm by immunofluorescent analysis. Sample: NT2D1 cells were fixed in ice-cold MeOH for 5 min. Green: PFKFB4 protein stained by PFKFB4 Polyclonal Antibody (Product # PA5-28648) diluted at 1:500. Blue: Hoechst 33342 staining.
- Submitted by
- Invitrogen Antibodies (provider)
- Main image

- Experimental details
- PFKFB4 Polyclonal Antibody detects PFKFB4 protein at cytoplasm by immunofluorescent analysis. Sample: NT2D1 cells were fixed in ice-cold MeOH for 5 min. Green: PFKFB4 protein stained by PFKFB4 Polyclonal Antibody (Product # PA5-28648) diluted at 1:500. Blue: Hoechst 33342 staining.
Supportive validation
- Submitted by
- Invitrogen Antibodies (provider)
- Main image

- Experimental details
- PFKFB4 Polyclonal Antibody detects PFKFB4 protein at cytoplasm on mouse spleen by immunohistochemical analysis. Sample: Paraffin-embedded mouse spleen. PFKFB4 Polyclonal Antibody (Product # PA5-28648) diluted at 1:500. Antigen Retrieval: EDTA based buffer, pH 8.0, 15 min.
- Submitted by
- Invitrogen Antibodies (provider)
- Main image
- Experimental details
- Immunohistochemical analysis of paraffin-embedded NCI-N87 xenograft, using PFKFB4 (Product # PA5-28648) antibody at 1:500 dilution. Antigen Retrieval: EDTA based buffer, pH 8.0, 15 min.
- Submitted by
- Invitrogen Antibodies (provider)
- Main image

- Experimental details
- Immunohistochemistry (Paraffin) analysis of PFKFB4 was performed in paraffin-embedded mouse testis tissue using PFKFB4 Polyclonal Antibody (Product # PA5-28648) at a dilution of 1:500.